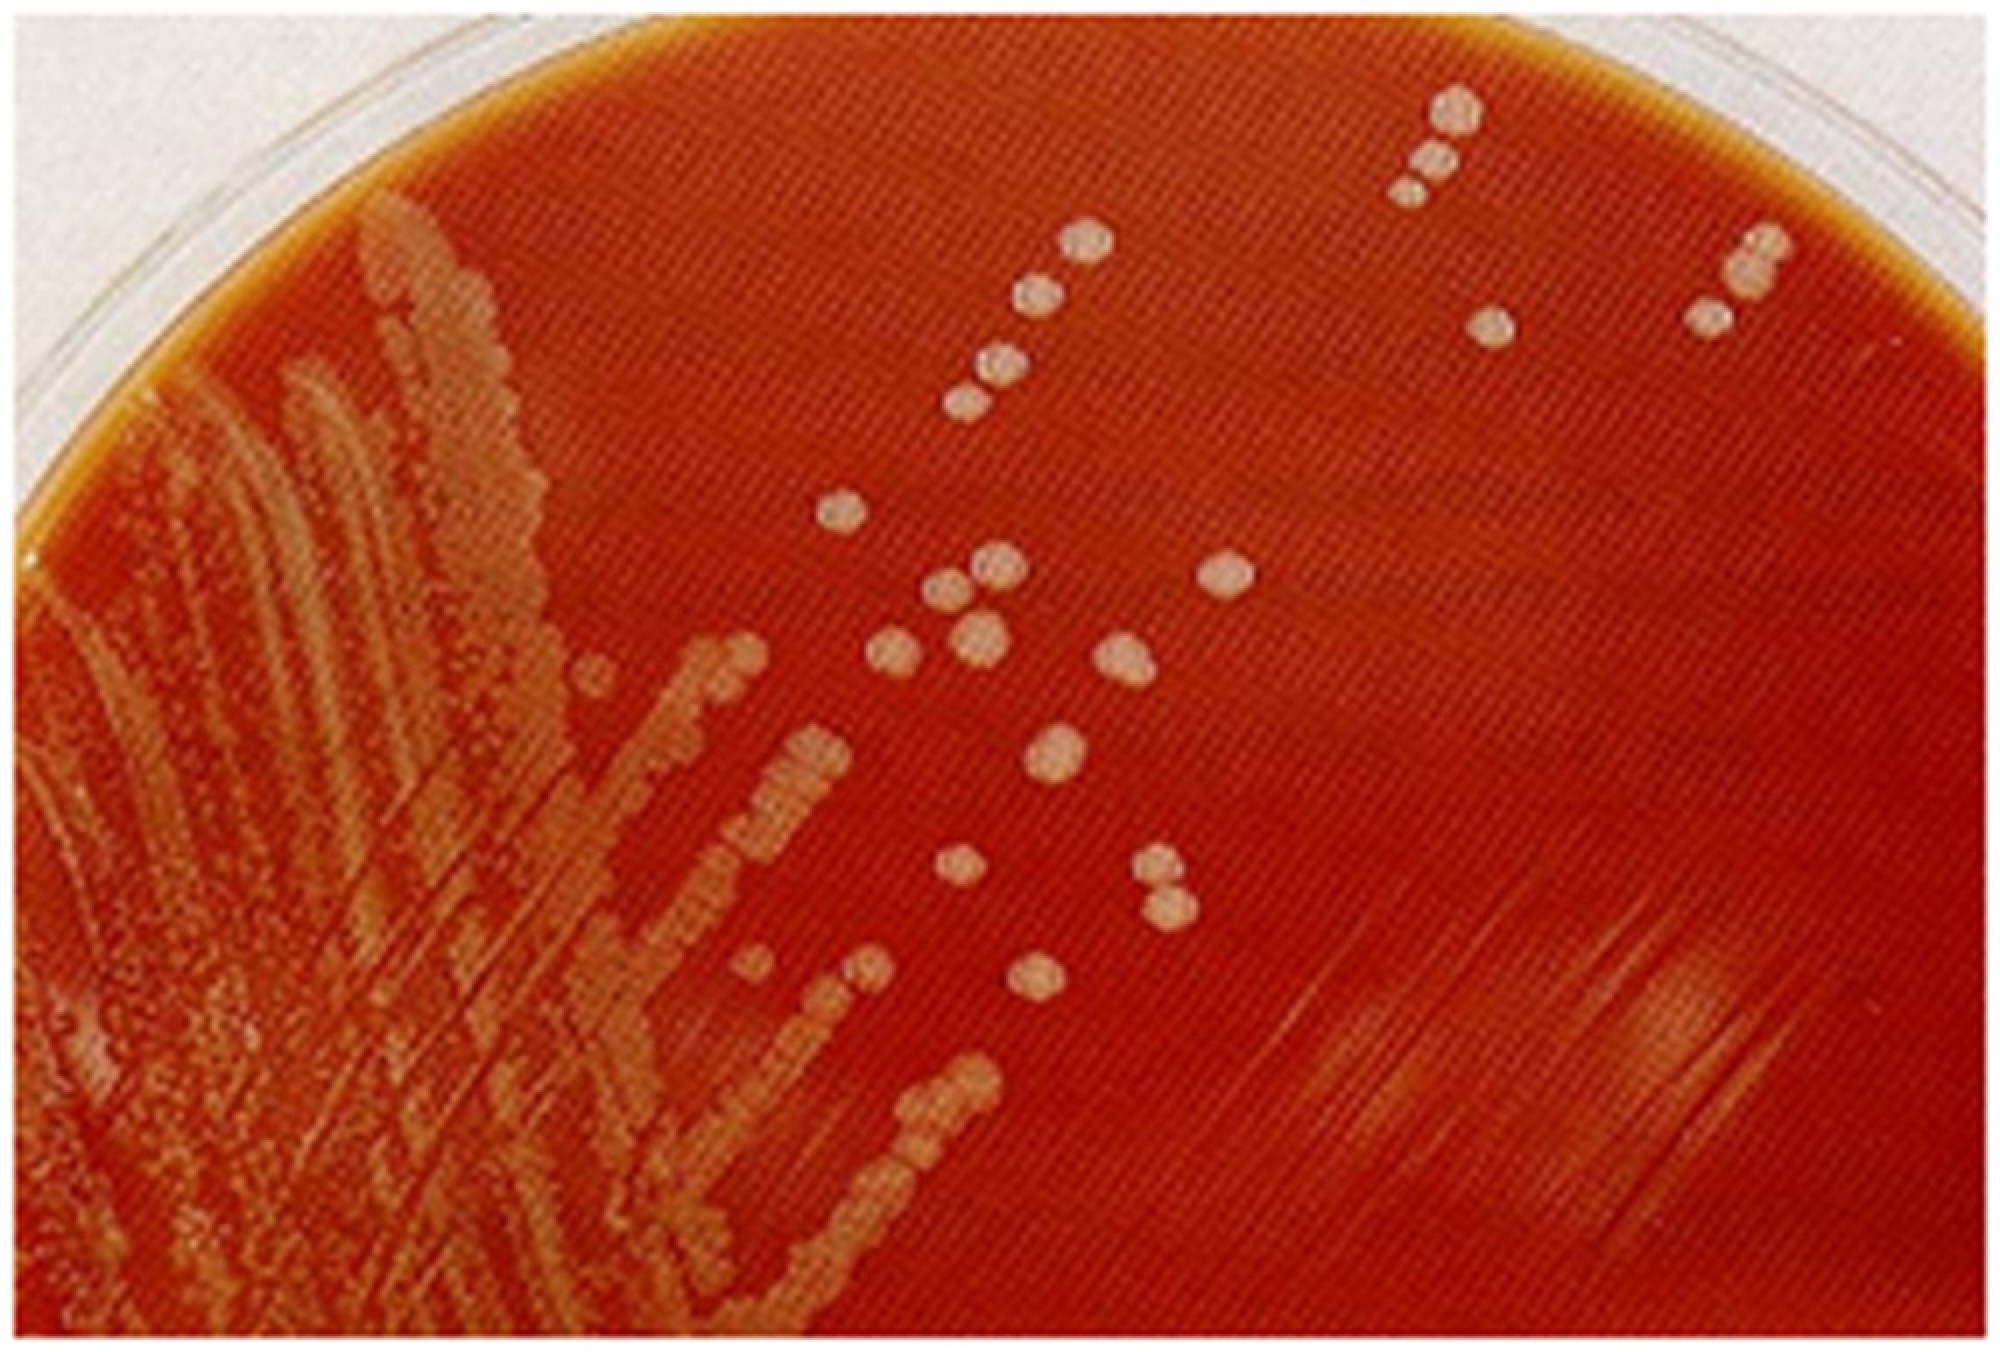
Medicine makes strides in battling meningococcal disease

The government’s Department of Medical Sciences is now able to confirm diagnoses of meningococcal disease within just 24 hours thanks to a laboratory technique called polymerase chain reaction (PCR).
Director-general Dr Sukhum Kanchanapimai said on Monday the more effective method – which creates millions of copies of a particular segment of DNA for testing – has also led to the discovery of a serogroup B strain of the disease, for which no vaccine is as yet available in Thailand.
Serogroup B was found in 10 people in 2016-2017, Sukhum said.

The PCR-based test is much faster than the complicated and costly latex agglutination test, which takes three to five days to produce results.
Sukhum said the Songkhla Medical Sciences Office’s PCR test could with high accuracy and within 24 hours detect serogroups A, B, C, Y and W135, which are responsible for the 90 per cent of cases.
Vaccines for A, C, Y and W135 are available in Thailand.
Neisseria meningitidis is divided into 13 serogroups, including the Neisseria meningitidis X that recently emerged in Africa.
The Bureau of Epidemiology under the Department of Disease Control last year reported 29 meningococcal disease cases in Thailand, which led to eight deaths.
The disease is affecting 0.04 people per 100,000, with the southern region having the most cases, especially Yala, Phattalung and Songkhla, Sukhum said.
Meningococcal meningitis is a potentially life-threatening infection of the membranes covering the brain and spinal cord.
It’s caused by the bacteria Neisseria meningitidis, also known as meningococcus.
The typical symptoms are sudden fever, headache, vomiting and neck stiffness. It can escalate to cause blood infection, purpuric rash, low blood pressure and organ failure.

